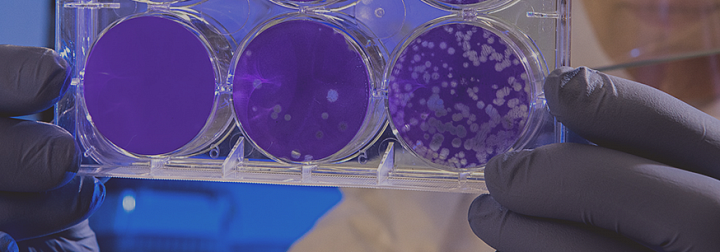

Маркировка и прослеживаемость
Внедрение единообразной маркировки товаров и других объектов учета на основе международных стандартов ― одно из базовых условий успешной цифровой трансформации производственных и логистических цепочек предприятия.
Кодификация и маркировка позволяют создавать реалистичные цифровые модели цепочек поставок, анализировать их, управлять реальными производственными процессами и эффективно их изменять. Внедрение системы логистической прослеживаемости является обязательным элементом инфраструктуры для компаний, которые планируют интегрироваться в глобальные производственно-сбытовые цепочки.
Эксперты Юникона оказывают полный комплекс услуг по внедрению системы маркировки и прослеживаемости товаров в производственных и торговых компаниях, решая следующие задачи:
- независимая защита подлинности товаров, изделий и комплектующих;
- интеграция с государственной системой маркировки товаров;
- контроль над сбытовыми каналами и внедрение новых логистических стратегий;
- создание цифровых моделей качества товаров;
- создание цифровой модели корпоративной социальной ответственности (КСО);
- организация зеленых таможенных коридоров для фреш-сегмента и другой подкарантинной продукции.
Наши бизнес-аналитики и ИТ-архитекторы имеют международный опыт внедрения систем прослеживаемости. В нашем арсенале — специализированная Track&Trace-система Shping Security, обеспечивающая быстрый и успешный старт для предприятий любого масштаба и любой отраслевой направленности.
Отличительной особенностью всех реализуемых компанией Юникон проектов является ориентир не только на выполнение обязательных требований со стороны государственных систем, но и достижение экономических эффектов за счет внедрения системы маркировки и прослеживаемости.
Внедрение системы маркировки и прослеживаемости с командой Юникона включает несколько этапов:
- Реинжиниринг бизнес-процессов в производстве, транспортной и складской логистике, закупках и сбыте, трансграничных операциях.
- Разработка и внедрение правил кодификации и маркировки товаров, материалов, тары, документов, оборудования и т. д.
- Дооснащение производственных и логистических участков оборудованием для маркировки и распознавания кодов.
- Внедрение, настройка и/или интеграция ИТ-систем (MES, ERP, WMS, TMS, CRM и др.).
- Изменение партнерских условий, бизнес-моделей и юридических схем при работе с прослеживаемой продукцией.
- Создание цифровых моделей качества и/или КСО для контроля над соблюдением технологии, условий хранения и транспортировки, а также для соблюдения требований деловых практик.
- Информационная кампания для клиентов и партнеров, новые маркетинговые механики и описательный контент, процессы выявления и обработки инцидентов.
Для реализации проектов по внедрению системы маркировки и прослеживаемости мы используем одно из передовых решений в данной области — Track&Trace-систему Shping Security.
Shping Security — это специализированная система прослеживаемости, позволяющая развивать и поддерживать транзакционные ИТ-системы без влияния требований со стороны процессов Track&Trace. Такой подход минимизирует фискальные и технологические риски компании.
Shping — это:
- Кросс-отраслевое ИТ-решение. Масштабируется типовым образом на произвольное количество товарных категорий в большинстве отраслей.
- Соответствие стандартам GS1. Систему возможно использовать в любой юрисдикции как для независимой защиты подлинности, так и с целью прослеживаемости.
- Детальное распределение операционных расходов. Продуманный прайсинг позволяет детально распределять затраты в любых аналитических разрезах, включая контрагентов, логистические сервисы, товарные категории и виды операций.
- Идеальная ценовая модель для прогнозирования затрат. Shping позволяет точно планировать затраты будущих периодов, стоимость сервисов и внешние цены на услуги и товары.
- Экосистемный масштаб охвата. Система позволяет бесшовно работать всем участникам цепочки поставок от бренда до ретейлера в едином информационном пространстве. Снижает издержки себестоимости товаров.
- Доступ к уникальным маркетинговым механикам для b2b/b2c-продукции. Система позволяет создавать уникальные конкурентные преимущества для товаров, маркировка которых имеется в Shping. Новейшие маркетинговые механики позволяют активировать целевую аудиторию, повысить частоту покупок и лояльность потребителей.
Работа с командой Юникона при внедрении системы маркировки и прослеживаемости позволит вам:
- сохранить целостность и эффективность действующих бизнес-процессов;
- осуществить точечный реинжиниринг процессов в местах учета кодов SGTIN/SSCC;
- сохранить действующую ИТ-архитектуру, исключая модификацию ERP и WMS-систем;
- использовать ранее действовавшие механизмы обмена данными и интеграции;
- минимизировать время и стоимость логистической обработки товаров;
- получить типовые интеграционные схемы для партнеров по бизнесу;
- извлечь дополнительные экономические выгоды от внедрения систем маркировки и прослеживаемости.